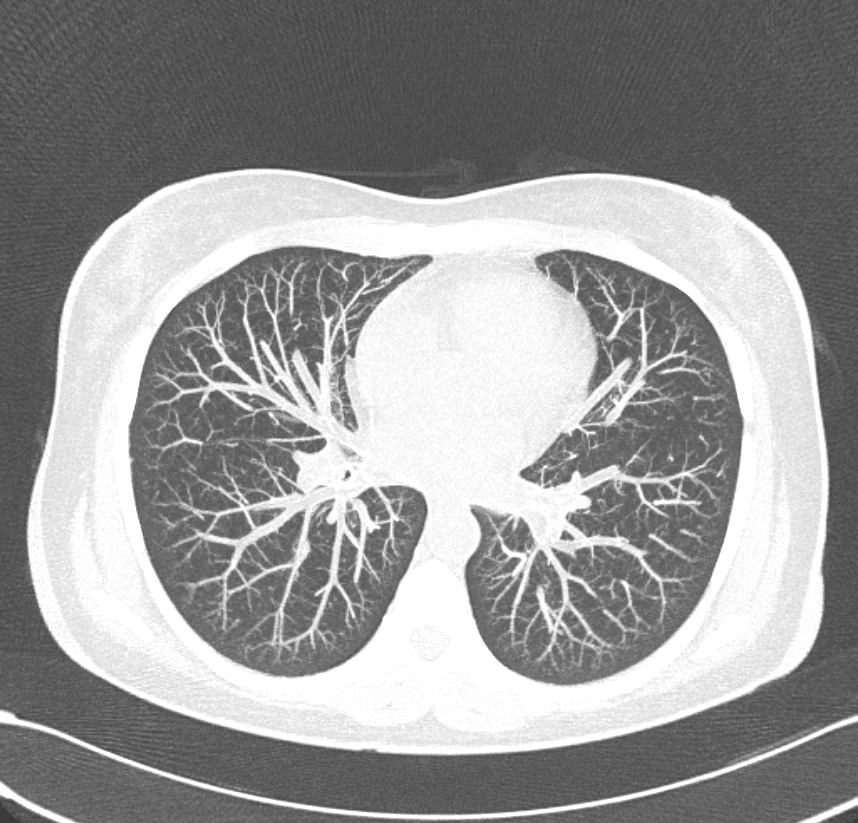
scanner3

Cabinet de Radiologie Clemenceau
Votre Scanner
à Benfeld ou Bergheim




Cabinet de Radiologie Clemenceau
Votre Scanner
à Benfeld ou Bergheim

Présentation du Scanner
Le scanner (tomodensitométrie / TDM) utilise les propriétés des rayons X pour obtenir une imagerie 3D de la zone anatomique étudiée.
Dans certains cas, il est utile d’injecter un produit de contraste iodé afin d’améliorer la performance diagnostique.
Si une injection est nécessaire, nous vous transmettrons avant votre rendez-vous une ordonnance (pharmacie) ainsi qu’une ordonnance de prise de sang pour vérifier votre fonction rénale. Une bonne hydratation dans les heures précédant l’examen est conseillée.
Des précautions doivent être prises en cas de grossesse : merci de le signaler avant l’examen.

En cas d’injection, une sensation de chaleur peut être ressentie : c’est normal et cela disparaît rapidement.
Présentation du Scanner
Le scanner (tomodensitométrie / TDM) utilise les propriétés des rayons X pour obtenir une imagerie 3D de la zone anatomique étudiée.
Dans certains cas, il est utile d’injecter un produit de contraste iodé afin d’améliorer la performance diagnostique.
Si une injection est nécessaire, nous vous transmettrons avant votre rendez-vous une ordonnance (pharmacie) ainsi qu’une ordonnance de prise de sang pour vérifier votre fonction rénale. Une bonne hydratation dans les heures précédant l’examen est conseillée.
Des précautions doivent être prises en cas de grossesse : merci de le signaler avant l’examen.


